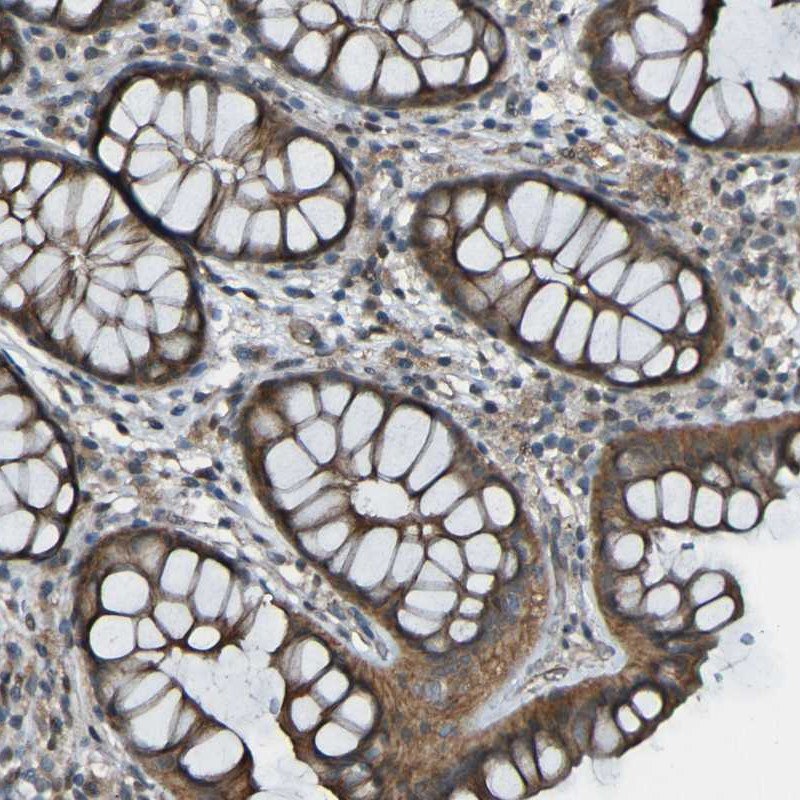
Immunohistochemical staining of human colon with anti-LGR5/GPCR49 polyclonal antibody (Cat. No. HPA012530) shows cytoplasmic positivity in glandular cells, in brown.

GPCR Markers for Cancer Research
G protein-coupled receptors (GPCRs) allow for the communication between the environment and the cell’s interior - they transduce extracellular stimuli into intracellular signals. GPCRs play an essential role in different physiological functions and have been well documented in many forms of cancer, contributing to cancer proliferation, angiogenesis, invasion, and metastasis. GPCRs are suitable biomarkers for the early diagnosis of cancer. The pharmacological inhibition of GPCRs and their downstream targets might provide an opportunity for the development of new, mechanism-based strategies for cancer prevention and treatment. Read on to explore the role of some selected GPCR markers in cancer research development and treatment.

What Are GPCRs?
G protein-coupled receptors (GPCRs) are also known as seven-transmembrane domain (7TM) receptors. They belong to a vast family of signaling proteins that mediate cellular responses to most hormones, metabolites, chemokines, and neurotransmitters.
With more than 800 identified members, the human GPCRs gene family remains the largest in mammals, including humans. Among the plethora of functions assigned to these proteins, one could mention mood and affective behavior, cardiovascular regulation, immunity and inflammation, olfaction, and pain 1. Among the 800 family members, only four proton-sensing receptors GPR132 (G2A), GPR4, GPR65 (TDAG8), and GPR68 (OGR1), are known to regulate acidity (pH) in the cellular environment 1. Except for protons, these receptors have no other known ligand and are hence called “orphan”.
The GPCRs that are known so far fall into six classes based on sequence and function:
- Class A: Rhodopsin-like receptors
- Class B: Secretin family
- Class C: Metabotropic glutamate receptors
- Class D: Fungal mating pheromone receptors
- Class E: cAMP receptors
- Class F: Frizzled (FZD) and Smoothened (SMO) receptors
GPCRs constitute the most significant and druggable therapeutic target category, in fact, any pharmaceutical drug in development targets a transmembrane receptor, mainly a GPCR 2,3. Finding new ways to modulate GPCR signaling to increase their efficacy and at the same time blocking the adverse effects remains an important and tremendous challenge in pharmaceutical development.
GPCRs in Cancer Research
GPCRs are attractive drug targets due to their relevance in a plethora of disease conditions 4. Despite a considerable body of information, GPCRs have not presented themselves as a valid “genetic driver” in cancer. Hence, GPCRs have remained neglected or at least understudied as molecular targets in oncology.
The past decades have experienced a changed perception towards the role of GPCRs in cancers. Today we know that aberrant GPCR expression may contribute to oncogenesis mechanisms, including metastasis, therapy resistance, and immune evasion. Yet surprisingly, few GPCR-based therapies have found their way to the oncologist at the clinic. Despite recent advancements in the structural and functional knowledge of GPCRs, only eight FDA-approved drugs target GPCRs for cancer therapy (Table 1) 5. Current and future research aim to discover the potential benefits of targeting GPCRs and their signaling circuits for the new era of precision medicine and cancer immunotherapies.
The first study of GPCRs and cancer was published in 1986 when a new human oncogene called MAS was noted for its tumorigenicity in nude mice 6. This protein was found to be very hydrophobic with seven potential transmembrane domains. In this respect, the structure of the MAS protein was a novelty among cellular oncogene products. For this reason, MAS constituted an entirely new functional class of oncogenes carrying no oncogenic mutations 6. The MAS1 proto-oncogene-like GPCR binds the neuroregulatory peptide angiotensin and is expressed in the testis, breast, cervical, lung, and pancreatic cancers 7.

Figure 1.Immunohistochemical staining of human testis with anti-MAS1L polyclonal antibody (Cat. No. HPA017983) shows strong positivity in basal cells of ductus seminiferous.
The first example of a classical GPCR neurotransmitter receptor with transforming properties was the serotonin 5HT1C-receptor (HTR1C) that, when expressed in mouse fibroblasts, generated sarcomas (tumors) 8. The identification of activating mutations in the thyrotropin receptor gene (TSHR) in hyperfunctioning thyroid adenomas provided more evidence that mutant GPCRs could initiate a neoplastic disease 9. The muscarinic acetylcholine (mAChRs) family of the GPCR rhodopsin-like receptors subtypes (CHRM1 (Cat. No. HPA014101), CHRM2, and CHRM3) reveals oncogenic potential. Ligand-stimulation of mAChRs linked to phosphatidylinositol hydrolysis can act as conditional oncogenes showing the transforming ability of mouse fibroblast 10.
Like other oncogenes, tumor-generating mutations also occur among GPCRs, such as for the α-adrenergic receptor 1B (ADRA1B, Cat. No. HPA074416) inducing tumor generation in nude mice 11. These early studies presented a new and unexpected role for GPCRs as capable of oncogenic transformation. More recently, another interesting example of a mutated GPCR turned tumorigenic is the cysteinyl-leukotriene receptor 2 (CysLTR2, Cat. No. HPA046528), which has a single mutation in transmembrane helix 3 (mutant CysLTR2-L129Q), causing uveal melanomas in humans 12.
Neurohormonal GPCRs
The two members of the bombesin family of regulatory peptides, gastrin-releasing peptide (GRP) and neuromedin B (NMB), are strongly implicated in cancer development 13,14. The GRP receptor (GRPR) has higher selectivity for GRP over NMB, whereas the NMB receptor (NMBR) has the reverse pattern.
These GPCR-ligands are highly expressed/produced in different tumors where they act as autocrine or paracrine growth factors. GRPR and NMBR are frequently overexpressed in colorectal tumors, gliomas and lung carcinomas, ovarian epithelial cancers, and neuroendocrine tumors of the gut and lung 15,16. Many of the growth stimulatory effects of these GPCRs are mediated through the transactivation of the tyrosine kinase receptors like the EGF and HER2 receptors, belonging to an entirely different class of transmembrane proteins with kinase activity 17.
Another category of neurohormonal GPCRs involved in cancer is the category of somatostatin receptors SSTR1 and SSTR2, expressed in both small cell (SCLC) and non-small cell lung cancer (NSCLC) 18. Radiolabeled SSTR2 analogs are utilized for radiographic imaging of tumors, which, in combination with PET-CT, provides improved lung cancer detection. SSTR2 analogs are also an interesting candidate for targeted chemotherapy and radiotherapy 19,20.

Figure 2.Immunohistochemical staining of human stomach with anti-SSTR1 polyclonal antibody (Cat. No. HPA031506) shows moderate to strong positivity in luminal membrane in glandular cells, in brown.

Figure 3.Immunofluorescent staining of human cell line A-431 with anti-SSTR2 polyclonal antibody (Cat. No. HPA007264) shows localization to cytosol, in green. Microtubules are shown in red and nuclei in blue.
GPCR and Oncoviruses
Oncoviruses are cancer-causing viruses. The human hepatitis B (HBV) and C (HCV), the human papillomaviruses (HPV), the Epstein–Barr virus (EBV), and the Kaposi sarcoma herpesvirus (KSHV) are the most important human oncoviruses currently known. Interestingly, some virally encoded and constitutively activated GPCRs promote and sustain tumorigenesis.
An example of GPCR and oncovirus is the “hijacked” GPCR known as KSHV-vGPCR (or ORF74). ORF74 is a highly constitutively active GPCR encoded and expressed by the HHV herpesvirus 8 (HHV8). ORF74 is involved in the pathogenesis of Kaposi’s sarcoma (a tumorous skin lesion in immunocompromised patients, including those with progressed HIV/AIDS) 21.
As for the “classical” oncogenes belonging to the kinase category, most were originally identified in retroviruses. The dawn of these studies opened a new door to establish the link between GPCRs and cancers.

Figure 4.Staining with anti-C2ORF74 polyclonal antibody (Cat. No. HPA026826). (A) Immunohistochemical staining of human stomach shows strong cytoplasmic positivity in parietal cells. (B) Immunofluorescent staining of human cell line U-251 MG shows positivity in centrosome and nucleus but excluded from the nucleoli.
Rhodopsin-Like GPCRs
The neuropeptide Y (NPY) is a neuropeptide that can also regulate the growth of various tumors. The NPY receptors belong to the class A or rhodopsin-like GPCR 22. Neuroblastoma and Ewing’s sarcoma (two pediatric tumor types) produce high levels of NPY. The hypoxic condition of the tumor microenvironment of these solid cancers upregulates and promotes the Y2R/Y5R NPY signaling axis 23. By stimulating the cognate receptors, Y2R and Y5R, NPY promotes the survival, migration, and angiogenesis of these neoplasias.
Another category of rhodopsin-like GPCRs involved in cancer is the tachykinin receptors, including the substance P receptor/NK1R/TACR1. Substance P induces tumor cell proliferation, angiogenesis, and cancer cell migration. Moreover, tumor cells frequently overexpress TACR1 (Cat. No. HPA074573). Interestingly, the TACR1 antagonist, aprepitant, shows promising anti-tumorigenic activity 24.

Figure 5.Immunohistochemical staining of human skin with anti-TACR1 polyclonal antibody (Cat. No. HPA074573) shows strong cytoplasmic positivity in epidermal cells in the basal layer.
Frizzled GPCRs and Wnt Signaling
The frizzled group of GPCRs is evolutionarily conserved and serves to transduce signals from the Wnt-type lipoprotein growth factors. Several cancers display dysregulated Wnt signaling pathways. Originally defined as a Wnt target gene, potentiating the canonical Wnt/β-Catenin signaling, the Leucine-rich repeat-containing G-protein-coupled receptor 5 (LGR5 or GPR49, Cat. No. HPA012530) represents an exquisitely specific and almost “generic” marker of normal stem cells in several tissues, including the intestine 25.
LGR5 has been proposed as an independent prognostic marker and as a therapeutic target for colorectal cancer, although, in this context, its role appears very complex 26.
Figure 6.Immunohistochemical staining of human colon with anti-LGR5/GPCR49 polyclonal antibody (Cat. No. HPA012530) shows cytoplasmic positivity in glandular cells, in brown.
Adhesion GPCRs
The adhesion G protein-coupled receptors (aGPCRs) constitute a large yet poorly understood family of seven-transmembrane proteins. There is ample evidence for the implication of tumor-associated adhesion-GPCRs in tumorigenesis. These receptors affect the growth of tumor cells, angiogenesis, tumor cell migration, invasion, and metastasis, either positively or negatively 27.
Additionally, some adhesion-GPCRs are considered to be potential biomarkers for specific types of cancers. ADGRG1/GPR56 is upregulated in some colorectal cancer tissues but shows anti-metastatic properties in melanoma via inhibition of cell-extracellular matrix signaling 28,29.
Another member of the adhesion GPCRs family involved in cancer is the glioma marker ADGRL4 (AMAb91268), which promotes glioblastoma through hypoxia signaling and is considered a target for anti-cancer therapy 30.
GPCRs and Chemokines
Chemokines are small soluble cytokines that guide the migration of other cell types, particularly immune cells. The chemokines have a plethora of important roles in cancer, not least in association with metastasis and tumor immunity 31. Most chemokines act through GPCRs and play critical roles in tumor growth, angiogenesis, invasion, and leukocyte infiltration into the tumor. One example includes CCL2 (Cat. No. HPA019163), a chemokine secreted from tumors acting through its receptor CCR2 to promote prostate tumor growth and stimulate tumor angiogenesis 32,33.
Most solid tumors undergoing metastasis do so via lymph nodes. One example is the chemokine (C-C motif) ligand 1 CCL1 (Cat. No. HPA049861) that attracts CCR8-positive distal tumor cells towards the lymph node 34. Strategies to block the ligand interactions with these GPCRs would be of great therapeutic value.
Chemokine/chemokine receptor signaling is also known to regulate tumor immunity. Hypoxia in the ovarian cancer tumor causes the induction of CCL28 (Cat. No. HPA077434). The upregulated CCL28 accelerated tumor growth by binding to its cognate GPCR, CCR10 (Cat. No. HPA013819), and activation of the immunosuppressive regulatory T-cells (Tregs) 35.
GPR132: A Potential Tumor Suppressor
The early GPCR-derived oncogene G2A, also known as GPR132 (Cat. Nos. HPA029694, HPA029695), is a member of the proton-sensing GPCRs subfamily. This GPCR induces a full range of phenotypes characteristic of oncogenic cellular transformation of mouse fibroblasts and tumorigenicity 36,37. Inhibition of GPR132 is a potentially novel treatment for reducing cancer metastasis. Loss of GPR132 in mice inhibits breast cancer metastasis, and lower GPR132 expression in patients with breast cancer correlates with better metastasis-free survival 38.

Figure 7.Immunohistochemical staining of a human lymph node with anti-GPR132 antibody (Cat. No. HPA029695) shows strong cytoplasmic positivity in non-germinal center cells.
References
To continue reading please sign in or create an account.
Don't Have An Account?